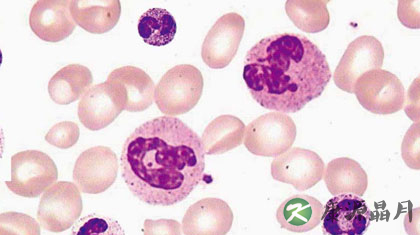
中性粒细胞百分比偏高的原因 中性粒细胞百分比偏高的原因

- 您好!欢迎来到康源名医金桥网

养生导读:大家知道一到春天漫天纷飞的蒲公英吧,飞到哪里,哪里就是你的家,这或许就是蒲公英一生的真实写照。蒲公英营养丰富,有利尿、缓泻、退黄疸、利胆等功效,其含有众多微量元素及维生素,对人体的功效不可忽视!今天大家就就一起来了解下蒲公英的功效吧!
蒲公英的功效与作用。
1、抗菌。
50%鲜草汁用平板挖沟法,对金黄色葡萄球菌、伤寒杆菌有抑制作用;50%全草煎剂用平板挖沟法,对金黄色葡萄球菌和绿脓杆菌有抑制作用。
2、抗真菌。
水浸液用试管稀释法,1:4对奥杜盎小孢子菌许兰黄癣菌,红色毛癣菌等有抑制作用。

3、抗肿瘤。
蒲公英热水提取物30-40mg/kg腹腔注射,对小鼠艾氏腹水癌皮下接种后11~20天给药有抑瘤作用,对接种后的1~10天给药无效,其抗肿瘤作用类似香菇多糖,是通过免疫机制实现的。
另外,本品还有抗胃溃疡、利胆、保肝等作用。
蒲公英的用途。
1、清热解毒,消肿散结。
a、实火热毒上攻,目赤咽肿,口舌生疮。
b、热毒疮疡,乳痈肿痛,疔毒内攻。
c、肺痈咳吐脓血,肠痈腹痛发热。
2、利湿。
可治热淋涩痛,及湿热发黄。

蒲公英泡水喝的功效与作用。
1、清热解毒可用于热毒证,尤善清肝热,治疗肝热目赤肿痛,以及多种感染、化脓性疾病。
2、消痈散结治疗热毒壅结于肌肉所致的痈肿疮毒,高热不退。对乳痈有良效,能解毒散结通乳,可内服或外敷,常配金银花等同用。另外还可配大黄、丹皮治疗肠痈。
蒲公英泡水喝主治:治急性乳腺炎,淋巴腺炎,瘰疠,疔毒疮肿,急性结膜炎,感冒发热,急性扁桃体炎,急性支气管炎、胃炎,肝炎,胆囊炎,尿路感染。
蒲公英是一种珍贵的中草药,性味苦、寒、甘,具有清热解毒、消痈散结、消炎、凉血、利尿、利胆、轻泻、健胃、防癌等很多种功能。主治:急性乳腺炎、腮腺炎、淋巴腺炎、瘰疠、疗毒疮肿、急性结膜炎、咽炎、感冒发烧、急性扁桃体炎、风湿性关节炎、急性支气管炎、胃炎、肝炎、肺炎、胆囊炎、急慢性阑尾炎、泌尿系统感染、骨髓炎、阴道炎、盆腔炎、十二指溃疡、痤疮、粉刺、结石症、以及多种癌症等数十种病症。

注意事项:阳虚外寒、脾胃虚弱者忌用。
1、用量过大常规用量煎服后,偶见有胃肠道反应,如恶心、呕吐、腹部不适及轻度泄泻。大剂量(30g/kg)灌服煎剂3天,可见实验兔子肝细胞及肾小管上皮细胞轻度浊肿,肾小管变窄,其它无明显改变。小鼠和兔亚急性毒性试验,尿中可出现少量管型,肾小管上皮细胞浊肿。
2、过敏反应服用蒲公英煎剂、蒲公英酒浸剂后,个别人会出现荨麻疹、全身瘙痒等过敏反应。蒲公英注射剂静脉滴注后,亦偶有寒战、面色苍白、青紫或精神症状。
小编导读:不知道大家有没有注意,血液化验单有一个指标,是中性粒细胞百分比。有些人的血液化验单显示中性粒细胞百分比偏高,到底是什么原因呢?中性粒细胞百分比偏高的原因一般是细菌感染,我们来了解一下。
中性粒细胞百分比偏高的原因
通常拿到一张血常规化验单,医生主要看三个数据:白细胞计数(WBC)、淋巴细胞百分比和中性粒细胞百分比,而白细胞计数就是常说的血象,后两者则是白细胞的分类。众所周知,白细胞是人体的“卫士”,专门帮助人体抵御细菌等外来入侵。不过,其实在这些卫兵里,有一队“精兵强将”更需要关注,那就是中性粒细胞。中性粒细胞进行战斗时总是冲在最前面,在人体免疫系统里有着举足轻重的作用,对于医生来说,看血液化验单不仅仅看白细胞有没有低于正常值,还要关注中性粒细胞的数量。
中性粒细胞是什么?中性粒细胞(neutrophilicgranulocyte)在瑞氏(Wright)染色血涂片中,胞质呈无色或极浅的淡红色,有许多弥散分布的细小的(0、2~0、4微米)浅红或浅紫色的特有颗粒。细胞核呈杆状或2~5分叶状,叶与叶间有细丝相连。其颗粒表面有一层膜包裹,可分1~4型,颗粒中含髓过氧化物酶(myeloperoxidase)、酸性磷酸酶、吞噬素(phagocytin)、溶菌酶、β葡糖苷酸酶、碱性磷酸酶等。中性粒细胞具趋化作用、吞噬作用和杀菌作用。
专家说,如果白细胞数量高于1万,炎症比较厉害,可以使用消炎药物、打吊瓶,白细胞数量低于4000,说明抵抗力比较低,退烧药等要少用。如果淋巴细胞百分比高,则是病毒感染;中性粒细胞百分比高,则是细菌感染。白细胞主要为中性粒细胞,中性粒细胞高的话一般白细胞也高,常见为感染,一般感冒都会导致增高。

感冒会导致中性粒细胞百分比增高
如果白细胞计数和中性粒细胞百分比都高,说明是细菌感染;白细胞计数低,淋巴细胞百分比高,则是病毒感染;如果白细胞计数正常或偏低,中性粒细胞百分比偏高,则可能既有病毒感染又有细菌感染。当然,这是基本判断方法,具体情况还需医生确定。
知道了中性粒细胞百分比偏高的原因,那么中性粒细胞偏低是怎么回事呢?一起来看看下面的解释。
一、中性粒细胞偏低的原因
1、革兰阴性杆菌感染,如伤寒、副伤寒。
2、某些病毒感染,如流感病毒。
3、慢性理化损伤、机体长期接触铅、汞、苯等;某些药物如氯霉素、合霉素;长期接受放射线及放化疗患者。
4、系统性红斑狼疮等自身免役性疾病。
5、再生障碍性贫血(再障)等血液病。
6、脾功能亢进、甲状腺功能亢进(甲亢)。
7、某些寄生虫病如疟疾、黑热病。
二、中性粒细胞偏低的危害
中性粒细胞偏低会导致骨髓发育不全、骨髓入侵(成少突神经胶质细胞的造白细胞组织增生、部分成髓细胞性白血病)、病毒感染、伤寒、副作寒、某些寄生虫病(疟疾、黑热病)、甲状腺机能亢进、脾功能亢进、瓦尔登斯特伦病、多发性骨髓瘤、费尔提综合征、贫血(缺铁、缺叶酸、维生素B12缺乏)、放射线(如:定位治疗)、粒细胞缺乏症(中毒:匹拉咪痛、吩噻嗪、保泰松、抗甲状腺药等;免疫-免疫变态反应性疾病;全身性疾病)。

三、中性粒细胞偏低怎么办
一般是这样的,中性粒细胞来源于骨髓的造血干细胞,在骨髓中分化发育后,进入血液或组织。在骨髓、血液和结缔组织的分布数量比是28:1:25,成年人血液中中性粒细胞的数量约占白细胞总数的55%一70%。中性粒细胞属多形核白细胞的一种,由于其数量在粒细胞中最多,因此有人将多形核白细胞指中性粒细胞。
该细胞内含许多弥散分布的细小的浅红或浅紫色的特有颗粒,颗粒中含有髓过氧化物酶、酸性磷酸酶、吞噬素、溶菌酶等。髓过氧化物酶是中性粒细胞所特有,即使在有强吞噬作用的巨噬细胞中也极少或完全没有这种酶。在细胞化学上,一般将这种髓过氧化物酶作为中性粒细胞的标志。
中性粒细胞具有很强的趋化作用。所谓趋化作用,就是细胞向着某一化学物质刺激的方向移动。对中性粒细胞起趋化作用的物质,称为中性粒细胞趋化因子。中性粗细胞膜上有趋化因子受体,受体与趋化因子结合,激活胞膜上的钙泵,细胞向前方伸出片足,使细胞移向产生趋化因子的部位。
看了以上的介绍,现在你知道中粒细胞偏低是怎么回事了吧。如体检中发现中粒细胞百分比偏低,要尽快查明原因,及早治疗哦。中性粒细胞偏高和中性粒细胞偏低都对身体健康有影响,那么中性粒细胞的正常值是多少才正常呢?一起来看看下面的回答吧。
中性粒细胞监测是尿常规检查中必检项目,中性粒细胞影响着我们的免疫系统功能,其是否正常有重要的参考意义。
一、中性粒细胞的正常值是多少
中性粒细胞的正常参考值:
参考值:0.40~0.75(40%~75%);(1.80~6.30)×109/L。
二、中性粒细胞的监测意义
1、增多
急性和化脓性感染(疖痈、脓肿、肺炎、阑尾炎、丹毒、败血症、内脏穿孔、猩红热等),各种中毒(酸中毒、尿毒症、铅中毒、汞中毒等),组织损伤、恶性肿瘤、急性大出血、急性溶血等。
2、减少
见于伤寒、副伤寒、麻疹、流感等传染病、化疗、放疗。某些血液病(再生障碍性贫血、粒细胞缺乏症、骨髓增生异常综合征)、脾功能亢进、自身免疫性疾病等。
三、中性粒细胞的作用
中性粒细胞在血液的非特异性细胞免疫系统中起着十分重要的作用,它处于机体抵御微生物病原体,特别是在化脓性细菌入侵的第一线,当炎症发生时,它们被趋化性物质吸引到炎症部位。由于它们是藉糖酵解获得能量,因此在肿胀并血流不畅的缺氧情况下仍能够生存,它们在这里形成细胞毒存在破坏细菌和附近组织的细胞膜。
由于中性粒细胞内含有大量溶酶体酶,因此能将吞噬入细胞内的细菌和组织碎片分解,这样,入侵的细菌被包围在一个局部,并消灭,防止病原微生物在体内扩散。当中性粒细胞本身解体时,释出各溶酶体酶类能溶解周围组织而形成脓肿。
中性粒细胞是血常规化验其中的一项,但是你会看血常规化验单吗?拿到血液化验单,通常病人都会很茫然,密密麻麻这么多数据,到底说明了什么?尤其是看到有几个升高或者下降的箭头,更是内心恐惧,不知道问题是否严重。
专家说,通常拿到一张血常规化验单,医生主要看三个数据,白细胞计数(WBC)、淋巴细胞百分比和中性粒细胞百分比,而白细胞计数就是常说的血象,后两者则是白细胞的分类。所以,中性粒细胞数量需关注。下面就教大家该如何看血常规化验单。
一、中性粒细胞数量需关注
众所周知,白细胞是人体的“卫士”,专门帮助人体抵御细菌等外来入侵。不过,其实在这些卫兵里,有一队“精兵强将”更需要关注,那就是中性粒细胞。中性粒细胞进行战斗时总是冲在最前面,在人体免疫系统里有着举足轻重的作用。对于医生来说,看血液化验单不仅仅看白细胞有没有低于正常值,还要关注中性粒细胞的数量。
如果白细胞计数和中性粒细胞百分比都高,说明是单纯的细菌感染;如果淋巴细胞百分比高,则是病毒感染;如果白细胞计数和淋巴细胞百分比高、中性粒细胞百分比低那就是既有病毒感染又有细菌感染。
血象中还会有嗜酸性细胞百分比和嗜碱性细胞百分比这两个数据,这主要是白血病的指标,嗜酸性细胞百分比高也可能是患者有过敏的情况。
还有两个需要关注的数据是红细胞计数(RBC)和血红蛋白浓度(HGB),如果低了就意味着贫血。红细胞增高则一般见于身体缺氧,血液浓缩,原发性、继发性红细胞增多症,肺气肿临床常见疾病。

二、中性粒细胞抗体的检测方法
可采集玻片凝集试验和试管凝集试验来检测凝聚的中性粒细胞,不像红细胞凝集试验,粒细胞凝集程序不需加抗球蛋白试剂,仅依赖中性粒细胞自身能量凝聚。采用新生儿自身免疫性中性粒细胞减少症母亲血清进行凝聚试验,能分析中性粒细胞特异的靶抗原,包括NAl/NA2,NBl/NB2,NCL,NDl,NEt,9a。
几种检测抗体的方法可用于检测抗完整中性粒细胞膜表面抗原的抗体。125L葡萄球菌蛋白和125L抗人IgG能同时检测中性粒细胞表面的IgG。用荧光素标记的抗人免疫球蛋白,以间接免疫荧光法也可检测中性粒细胞抗体。临床可疑自身免疫性中性粒细胞减少患者的血清中,抗中性粒细胞抗体的阳性率约为35%。阳性患者需做追加试验,用高速离心法去除免疫复合物,并且用Fc受体相应的单克隆抗体封闭免疫复合物,再检测抗中性粒细胞抗体。
抗中性粒细胞抗体也能与正常骨髓髓样前体细胞反应,严重的中性粒细胞减少症患者血清易与不成熟的髓样前体细胞反应,同时对成熟粒细胞也反应。
鉴定特异抗中性粒细胞靶分子技术包括:蛋白质印迹法、免疫沉淀法和抗原捕获法,抗原捕获法用单克隆抗体在聚丙乙烯珠或多孔反应板内固定中性粒细胞膜分子,这些固定的分子经血清孵育,抗免疫球蛋试剂检测特异抗体。
以上为大家介绍了中性粒细胞的各种常识,你都了解了吗?中性粒细胞与身体健康有着密切的联系,了解中性粒细胞知识很重要。
 豫公网安备 41110202000246号互联网药品信息服务资格证书:(豫)-经营性-2022-0039增值电信业务经营许可证:豫B2-20221313医疗器械经营备案编号:豫郑食药监械经营备20212188号
豫公网安备 41110202000246号互联网药品信息服务资格证书:(豫)-经营性-2022-0039增值电信业务经营许可证:豫B2-20221313医疗器械经营备案编号:豫郑食药监械经营备20212188号




